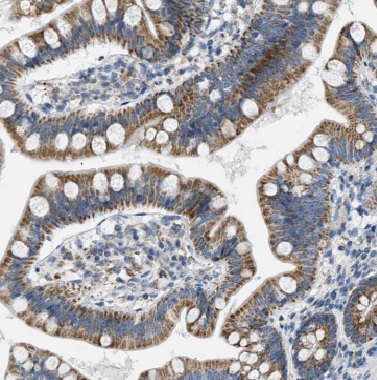
R3HCC1L antibody|R3HCC1L抗体

相关产品推荐更多 >
万千商家帮你免费找货
0 人在求购买到急需产品
- 详细信息
- 文献和实验
- 技术资料
- 免疫原:
chromosome 10 open reading frame 28
- 亚型:
IgG
- 形态:
liquid
- 保存条件:
PBS with 0.02% sodium azide and 50% glycerol pH 7.3, -20℃ for 12 months(Avoid repeated freeze / thaw cycles.)
- 克隆性:
多克隆抗体
- 适应物种:
Human
- 保质期:
-20℃ for 12 months(Avoid repeated freeze / thaw cycles.)
- 抗原来源:
chromosome 10 open reading frame 28
- 目录编号:
FNab00998
- 级别:
科研
- 库存:
100
- 供应商:
武汉菲恩生物科技有限公司
- 宿主:
Rabbit
- 应用范围:
ELISA, WB, IHC, IF
- 靶点:
chromosome 10 open reading frame 28
- 抗体英文名:
R3HCC1L antibody
- 抗体名:
R3HCC1L antibody
- 规格:
50μg/100μg
| 规格: | 50μg | 产品价格: | ¥1050.0 |
|---|---|---|---|
| 规格: | 100μg | 产品价格: | ¥1750.0 |

R3HCC1L antibody|R3HCC1L抗体宿主来源于Rabbit,克隆性:polyclonal,适用种属:Human,验证应用:ELISA, WB, IHC, IF
-------------------------------------------------------------------------------------------------------------------------
产品介绍
| 产品名称 | R3HCC1L antibody |
|---|---|
| 货号 | FNab00998 |
| 规格 | 50μg, 100μg |
| 纯化方法 | Immunogen affinity purified |
| 纯度 | ≥95% as determined by SDS-PAGE |
| 宿主 | Rabbit |
| 克隆性 | polyclonal |
| 亚型 | IgG |
| 存储 | PBS with 0.02% sodium azide and 50% glycerol pH 7.3, -20℃ for 12 months(Avoid repeated freeze / thaw cycles.) |
| 分子量 | 110 kDa |
| Uniprot ID | Q7Z5L2 |
| 适用种属 | Human |
| 验证应用 | ELISA, WB, IHC, IF |
| 建议稀释比例 | WB: 1:500-1:2000; IHC: 1:20-1:200; IF: 1:20-1:200 |
| 图片 | ![]() Immunohistochemistry of paraffin-embedded human small intestine tissue slide using FNab00998(C10orf28 Antibody) at dilution of 1:50 |
![]() A549 cells were subjected to SDS PAGE followed by western blot with FNab00998(C10orf28 Antibody) at dilution of 1:300 |
|
| 注意事项 | R3HCC1L antibody|R3HCC1L抗体仅供科研使用 |

风险提示:丁香通仅作为第三方平台,为商家信息发布提供平台空间。用户咨询产品时请注意保护个人信息及财产安全,合理判断,谨慎选购商品,商家和用户对交易行为负责。对于医疗器械类产品,请先查证核实企业经营资质和医疗器械产品注册证情况。
文献和实验Purification of Antibody Light Chains by Metal Affinity and Protein L Chromatography
Immobilized metal affinity chromatography (IMAC), introduced in 1975 (1 ), relies on the formation of coordinate bonds between metal ions immobilized on a suitable support and electron donor groups in proteins. A polyhistidine tag
Analysis and Purification of Antibody Fragments Using Protein A, Protein G, and Protein L
Today, monoclonal antibodies (mAbs) form the largest category of biopharmaceuticals in clinical trials and their number is expanding rapidly (DataMonitor 2007). The antibodies or functional antibody fragments are being produced in artificial
在免疫反应方面,基于抗原的刺激在体内形成、并与抗原作特异性结合的蛋白质之总称。其化学实质是免疫球蛋白。抗体,按照抗原抗体反应的类型可分别称为沉淀素、凝集素、溶血素、溶菌素、抗毒素、中和抗体等,但这些并不等于有相应的不同抗体存在,一般多只表明抗体反应的多样性而已。抗体在血清中含量最多(体液抗体=humoral antibody);含有某特定抗体的血清称为抗血或免疫血清。
技术资料暂无技术资料 索取技术资料